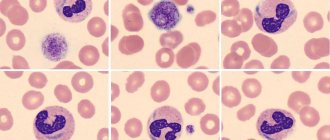

Что за клетки нейтрофилы?
Нейтрофильные лейкоциты или нейтрофилы являются самым многочисленным видом белых кровяных клеток. Они образуются в костном мозге, где проходят ряд стадий при созревании.
Из клетки-предшественницы образуется миелобласт. Следующей клеткой является промиелоцит. Из него образуется миелоцит, а далее метамиелоцит. Эти нейтрофилы называется юными. Из них созревают палочкоядерные формы. Далее из них формируются зрелые клетки – сегментоядерные нейтрофилы.
Все виды нейтрофильных лейкоцитов отличаются между собой на разных стадиях: формой ядра, наличием гранул. Так, например, сегментоядерные нейтрофилы содержат ядро, разделённое на сегменты.
Гранулы, содержащиеся в цитоплазме нейтрофилов, обеспечивают их возможность выполнять свои биологические функции.
Наличие гранул в цитоплазме нейтрофилов позволяет их отнести к гранулоцитарным лейкоцитам. Помимо нейтрофилов к ним также относятся эозинофилы и базофилы.
Главной задачей этих клеток является борьба с чужеродными агентами, проникающими в наш организм. Поэтому имеется зависимость между содержанием этих лейкоцитов и наличием инфекционного процесса.
Фото: https://moyakrov.info/blood/prichiny-povysheniya-ili-ponizheniya-segmentoyadernyh-nejtrofilov
Нормы содержания нейтрофилов у детей
Содержание нейтрофилов у детей в норме представлено в таблице 1. Представлены два основных вида нейтрофильных лейкоцитов: палочкоядерные и сегментоядерные. Также единицы измерения данного вида клеток будут представлены в виде относительных и абсолютных величин.
Абсолютные величины показывают содержание данного типа клеток в крови, выраженное как 10*9 на литр. Относительные цифры показывают какое число клеток данного вида было обнаружено из 100. Тогда единицей измерения будут являться проценты.
Таблица 1. Норма нейтрофилов у детей.
| Возрастная группа | Абсолютные значения | Относительные значения | |
| Палочкоядерные | Сегментоядерные | ||
| Менее одного года | 1,5 – 8,5 * 10*9/литр | 0,5 – 4 % | 15 – 45 % |
| Один год – шесть лет | 1,5 – 8,5 * 10*9/литр | 0,5 – 5 % | 25 – 60 % |
| От семи до двенадцати лет | 1,8 – 8 * 10*9/литр | 0,5 – 5 % | 35 – 65 % |
| Старше тринадцати лет | 1,8 – 7,7 * 10*9/литр | 0,5 – 6 % | 47 – 72 % |
Лечение
Терапевтическая программа направлена на укрепление иммунитета. С лечебной целью могут назначаться:
- витамины (Витрум, Компливит детский);
- усиленное питание – упор делается на овощи и фрукты, белковые продукты;
- лечебная гимнастика – подойдут подвижные игры, плавание, бег;
- при наличии сопутствующего заболевания принимают антибиотики, адсорбенты, иммуномодуляторы.
Последнюю группу препаратов назначает только врач после выявления основной патологии. Главная задача лечения – повысить нейтрофилы в крови и не допустить развития осложнений.
Защитные тельца у ребенка снижаются при острых и хронических патологиях. Редко такое состояние является врожденным. Чаще всего страдают молодые сегментоядерные формы. При развитии отклонения следует обращать внимание на лимфоциты, повышение количества которых говорит о вирусном заболевании. Лечиться необходимо сразу. Показаны укрепляющие препараты и оздоровительные процедуры.
Автор: Денис Филин, врач, специально для Mama66.ru
Почему нейтрофилы понижены у ребенка
Большую часть среди нейтрофилов составляют сегментоядерные. Поэтому причинами того, что сегментоядерные понижены могут быть:
- нарушение образования нейтрофильных лейкоцитов в костном мозге, например, в результате злокачественного процесса;
- быстрая гибель нейтрофилов после выполнения их функции – уничтожения инфекционного агента. То есть при избытке патогенных агентов организм не успевает выработать новые клетки, их содержание снижается;
- изменение количества других видов лейкоцитов, в результате чего изменяется относительное значение клеток. Поэтому в данном случае лучше учитывать абсолютные значения клеток в крови.
Снижение содержания нейтрофильных лейкоцитов называется нейтропенией.
Таким образом, наличие некоторых инфекционных заболеваний сопровождается тем, что сегментоядерные нейтрофилы понижены у детей. Примерами таких заболеваний могут быть:
- краснуха;
- гепатит;
- ветрянка;
- грипп;
- грибковая инфекция и другие.
Фото: https://pixabay.com/photos/cold-headaches-health-influence-3861935/
Сегментоядерные нейтрофилы ниже нормы
При расшифровке лейкоцитарной формулы в общем анализе крови большое внимание отводится соотношению различных форм нейтрофилов. Изменение их количества относительно друг друга называется сдвигом. Этот показатель очень важен при диагностике различных заболеваний.
Сдвиг лейкоцитарной формулы может быть влево (преобладают молодые формы) и вправо (уровень молодых нейтрофилов ниже стареющих форм, что значит норму).
У ребёнка в крови
При сдвиге лейкоцитарной формулы влево относительное количество сегментоядерных нейтрофилов может уменьшаться в пользу молодых и незрелых видов (метамиелоцитов, миелоцитов и палочкоядерных). Оценивать следует и общее количество лейкоцитов, ведь соотношение может не меняться, в то время как общее количество будет прогрессивно пониженным вплоть до «провала».
Изменения в лейкоцитарной формуле могут быть нормальным ответом организма на воздействие патогенного фактора. В другом случае, особенно при появлении в анализах дегенеративных форм, резко отличающихся от нормальных, указывает на резкое ухудшение состояния ребёнка и требует незамедлительного вмешательства и выяснения причин.
Строение сегментоядерного нейтрофила
У грудничка
Грудные дети хорошо защищены от проникновения инфекции, ведь с молоком матери поступает много иммунных клеток, которые успешно справляются с бактериями и вирусами. Если малыш на искусственном вскармливании, то риск развития заболеваний и осложнений после них увеличивается.
При рецидивирующих инфекциях у маленького ребёнка возможно развитие нейтропении с появлением необычных сегментоядерных нейтрофилов – двуядерных. Если количество сегментов снижено, то это обусловлено их гибелью и перераспределением в крови и тканях в ходе борьбы с патогенными микроорганизмами. Если болезнь длительно не проходит, то наступает истощение: активные клетки иммунитета уже погибли, а новые синтезироваться не успели. Нормальный уровень гемоглобина у ребенка.
Одной из наиболее распространённых причин, почему сегментоядерные нейтрофилы понижены, помимо тяжёлых инфекций, является аутоиммунный процесс в организме грудничка. Он развивается из-за собственных врождённых проблем с иммунитетом (системная красная волчанка, ревматоидный артрит) или в результате резус-несовместимости матери и плода по антигенной структуре.
Следует быть внимательным к назначаемым маленьким детям препаратам, потому что применение некоторых лекарств может привести к агранулоцитозу (критическое снижение уровня сегментоядерных лейкоцитов). Особенно это касается антибиотиков сульфаниламидной группы (бисептол) и нестероидных противовоспалительных средств, используемых в педиатрической практике (анальгин, ибупрофен).
У новорожденного
Для правильной интерпретации анализа следует знать, что до 3-7 дня у новорождённого ребёнка количество сегментоядерных нейтрофилов и лимфоцитов такое же, как и у взрослого. После этого происходит первый физиологический перекрёст и наступает состояние относительной нейтропении в сочетании с абсолютным лимфоцитозом (повышенное содержание).
Если количество сегментоядерных нейтрофилов в крови у новорожденного ребёнка понижено, родителям следует быть настороженными в отношении врождённых и наследственных форм заболевания.
К таким болезням относятся:
- младенческий агранулоцитоз;
- врождённая циклическая нейтропения (заболевание интересно тем, что каждые несколько недель наблюдается снижение количества нейтрофилов);
- доброкачественная этническая семейная нейтропения (характерна для нескольких определённых групп населения).
Когда детей направляют на анализ
Определение уровня нейтрофилов в крови входит в такой показатель, как лейкоцитарная формула. Он представляет собой подсчёт разновидностей лейкоцитов. Подсчёт лейкоцитарной формулы входит чаще всего в ОАК (общеклинический анализ крови).
Назначение данного анализа крови происходит для того чтобы:
- оценить состояние ребёнка в отсутствие каких-либо жалоб, при профилактическом осмотре;
- выявить наличие инфекционного процессе при подозрении на него, особенно, когда имеются клинические проявления;
- выявить нарушения содержания клеток крови в результате наследственного нарушения или опухолевого процесса.
То есть ОАК является простым, но достаточно информативным анализом крови, который назначается в профилактических целях, а также при любом заболевании.
Функция нейтрофилов и показания к их определению
Лейкоцитарная формула дает общее представление об иммунитете человека и включает в себя гармоничное соотношение пяти лейкоцитов: моноцитов, эозинофилов, лимфоцитов, нейтрофилов и базофилов. Нарушение нормы этих показателей в общем анализе крови помогает распознать патологии, вплоть до злокачественных новообразований.
Показаниями к проведению общего анализа крови, в частности, для определения количественного соотношения нейтрофильной фракции являются следующие заболевания:
- болезни верхних дыхательных путей (ангина и пневмония);
- патологии паренхиматозных органов (панкреатит и холецистит);
- сепсисы, гангрены и обширные ожоговые поражения кожных покровов;
- инфаркт;
- туберкулез;
- гипопластическая и апластическая анемия;
- кровопотери;
- аппендицит и перитонит;
- химические отравления;
- ревматические атаки.
Лейкоциты в целом выполняют защитную функцию организма: создают барьер для патогенной микрофлоры (инфекций, вирусов и бактерий), а также призваны поглощать болезнетворные бактерии, продукты их жизнедеятельности и распада.
Когда в организм человека попадает вирус или начинается воспалительный процесс, то повышается температура тела, таким образом иммунная система борется с возбудителем. Подробнее читайте в статье: «снизить температуру тела в домашних условиях».
Лейкоцитарный защитный барьер подразумевает сложное функционирование отдельных фракций, каждая из которых выполняет строго свои функции. Так, в задачу нейтрофилов входит поглощение патогенных микроорганизмов и расщепление их в собственном теле. Выполнив свою «миссию» нейтрофильный лимфоцит погибает, образуя экссудат и привлекая другие лейкоцитарные клетки. При этом нейтрофил выделяет антибактериальные вещества и ферменты.
Механизм прост: если в организме существует очаг воспаления, сегментоядерный (взрослый) нейтрофил из крови направляется к патогенному очагу, поэтому его количественное соотношение с остальными лейкоцитами в кровяном потоке может временно снижаться. Резкое же снижение уровня клеток в некоторых случаях происходит по причине интенсивных терапевтических методов, таких как радиационная или химическая терапия.
Подготовка к анализу
Для того чтобы узнать количество нейтрофильных лейкоцитов, нужно сдать кровь из пальца или из вены. Данный биологический материал необходимо сдавать натощак у детей старше пяти лет. Грудных детей рекомендуется не кормить в течение 30 минут до забора крови, а детей до пяти лет – в течение 3 – 4 часов.
Также желательно, чтобы пациент не испытывал эмоциональный перегрузки. Родителям следует замотивировать ребёнка выдержать «укол пальчика», объяснить, что ничего страшного в этом нет.
Родители также должны проследить, чтобы ребёнок не бегал по коридорам больницы перед забором крови.
Ручки у малыша должны быть тёплые. Если они будут холодными, кровь будет плохо течь из пальца, доставляя неудобство медицинскому персоналу и ребёнку.
Фото: https://pixabay.com/photos/nurse-diabetes-diabetic-test-a1c-527615/
Анализ крови и его интерпретация
Реклама:
Общий анализ крови позволяет определить процентное соотношение нейтрофильной фракции с остальными клетками. Забор крови проводят стандартно: из вены или пальца в утреннее время на голодный желудок.
Нейтрофилы больше реагируют на бактериальную инфекцию, а лимфоциты — на вирусную.
Исходя из функциональных особенностей лейкоцитов и их соотношения, судят о характере заболевания:
- при острой вирусной инфекции, сегментоядерные нейтрофилы понижены, а лейкоциты и лимфоциты повышаются;
- при хронизации ОРВИ сегментоядерные клетки и лейкоциты понижены, а лимфоциты повышены;
- при бактериальном поражении организма соотношение меняется в противоположную сторону: лейкоциты и нейтрофилы повышаются, а лимфоциты, наоборот, будут понижены.
При этом общий уровень моноцитов, эозинофилов и базофилов при ОРВИ повышается незначительно и диагностируется редко, в основном при беременности. Для выявления же подобных воспалительных процессов принимают в учет СОЭ — скорость оседания эритроцитов.
Бактериальное поражение имеет более сложную биологическую форму, в отличие от вирусной природы заболевания. Поэтому посредством выявления количества нейтрофильной фракции достоверно определяют опасные заболевания, вызванные: кишечной палочкой, палочками Коха и Леффлера, клостридиями, бледной трепонемой.
Методика определения уровня нейтрофилов в крови
Большинство анализов в современной лаборатории выполняют анализаторы. Определение количества нейтрофилов может быть произведено на автоматическом гематологическом анализаторе.
Другой вариант определения количества нейтрофильных лейкоцитов – ручной способ подсчёт лейкоцитарной формулы. Делается мазок крови окрашивается специальными красителями, которые позволяют идентифицировать различные виды белых кровяных клеток между собой.
Затем при помощи микроскопа считается 100 клеток в поле зрения, параллельно отмечая, какие клетки были увидены. Затем указывается относительно значение каждого найденного лейкоцита в мазке.
В мазке крови можно увидеть разные степени зрелости нейтрофилов, а также базофилы, эозинофилы, лимфоциты, моноциты, морфологические особенности эритроцитов (размер и форма).
Расшифровка анализа
Расшифровка результатов исследования должна осуществляться только врачом. Он учтёт все нюансы:
- какое состояние ребёнка на момент обращения;
- есть ли жалобы;
- данные других исследований крови или мочи;
- данные осмотра ребёнка;
- наследственность.
В лабораторной практике встречаются высокие и низкие значения нейтрофилов. Выше уже было указано, какие причины могут способствовать низкому уровню нейтрофилов в крови.
Высокое содержание нейтрофилов говорит о том, что в этот момент организм борется с инфекцией. Все «бойцы» ушли на борьбу с патогенным агентом. И такое состояние называется нейтрофилёз.
Как повысить нейтрофилы
Купить лекарство, способное повысить уровень нейтрофилов, невозможно. Однако повлиять на их содержание в крови все же можно. Например, если снижение клеток-фагоцитов произошло на фоне приема сульфаниламидных антибиотиков, имеет смысл пересмотреть с лечащим врачом курс терапии и заменить препараты.
В отдельных случая на выработку нейтрофилов влияет выраженный дисбаланс питательных веществ в организме. Чаще всего говорят о значительном снижении уровня витамина B9, известного как фолиевая кислота, и B12. Поэтому нередко при недостатке нейтрофилов дополнительно берут анализ на дефицит витаминов и прописывают курс группы B. Спустя 10-14 дней после восстановления баланса питательных веществ в организме наблюдается рост числа нейтрофилов, который фиксируется в пределах допустимых значений.